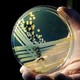

The Shame of College Sports
College quarterbacks are denounced for partying with agents or trading autographs for tattoos, but the real scandal is the NCAA’s fundamentally unjust concept of amateurism.
How the NCAA is exploiting players, Russia's Silicon Valley, political sex scandals, and more

College quarterbacks are denounced for partying with agents or trading autographs for tattoos, but the real scandal is the NCAA’s fundamentally unjust concept of amateurism.

As the list of politicos laid low by sexual scandal grows longer, history offers lessons on when the press should opt for exposure—and when it should leave well enough alone.

Outside Moscow, the Kremlin is making plans for a Russian Silicon Valley. But while tech companies are on board, the Russian people are less enthusiastic.
What happens when you gather the world’s most imaginative minds under one roof?
In today’s expanding cities, social skills are becoming ever more essential to economic growth.

A good-looking governor seeks to make Mexican voters forget the corrupt past of their old ruling party.

Why old stuffed rhinos now command top dollar

Wearing earplugs could have saved the author’s hearing, but at the cost of his soul.

Can scientists beat malaria by reengineering the mosquito?

Postcard from an awakened city

The author tries—and fails—to cash in on a big idea.

It’s easy, with the help of good new products and even better books.

The most enlightening way to cross the Mediterranean is by boat.

Second Life’s creator wants to rewire how businesses run.
We won’t stop the rising tide of infections until we develop a new business model to fight them.

Our obsession with musical nostalgia is strangling pop.
Ambrose Bierce’s astringent prose style reflects the severity of his vision.

Are menopausal women mad, bad, and dangerous? Yes—but they’re really just returning to normal.

David Lodge’s new novel of H. G. Wells’s very active love life

The brilliant foreignness of Australian crime fiction

Responses and reverberations